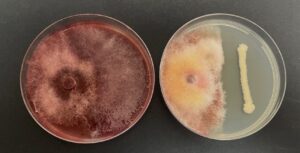

Fuzariozna palež klasa predstavlja jednu od najzastupljenijih bolesti pšenice sa aspekta ekonomskih gubitaka. Izazvana gljivama iz roda Fusarium spp., bolest se svake godine javlja u različitom intenzitetu, u zavisnosti od vremenskih uslova tokom cvetanja i sazrevanja zrna, prvenstveno količine padavina i temperature.
Posledice infekcije se ogledaju u smanjenju prinosa i pogoršanju kvaliteta zrna. U godinama sa povoljnim uslovima za razvoj bolesti, gubici kod osetljivih sorti mogu dostići i do 50%. Zrna su sitna, loše razvijena, smanjene hektolitarske mase i često kontaminirana mikotoksinima, zbog čega nisu pogodna za ishranu ljudi i životinja.
U cilju prevencije infekcije, kompanija Agrounik je razvila Fuzarix, inovativni biofungicid na bazi korisnih mikroorganizama.
Preparat se primenjuje na početku cvetanja, kada oko 5% klasova razvije prašnike, u količini od 3 l/ha. Može se koristiti samostalno ili u kombinaciji sa drugim sredstvima za zaštitu bilja.
Za maksimalan efekat tretmana preporučuje se istovremena primena preparata:
Slavol – 5 l/ha (povećanje prinosa i kvaliteta)
Amiksol – 2 l/ha (otpornost biljaka)
Bionix – 2 l/ha (prevencija lisnih vaši)

Integrisana primena ovih preparata omogućava efikasnu zaštitu pšenice, očuvanje kvaliteta zrna i ostvarenje visokih prinosa.








